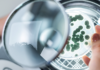
Manejo biológico da semente à colheita eleva a sustentabilidade e a ecoefiência da produção

A pulverização é um dos momentos mais importantes no manejo da lavoura. A aplicação de defensivos agrícolas de forma inadequada pode deixar a cultura vulnerável a doenças e resultar em perdas na produtividade e na rentabilidade do agricultor. Um estudo do Instituto de Desenvolvimento Rural do Paraná (IDR-PR) mostrou que 46% das aplicações de defensivos agrícolas são desperdiçadas por erros humanos.
Segundo Lucas Zanetti, coordenador de Marketing Tático da Massey Ferguson, maior fabricante de máquinas agrícolas da América Latina e referência no mercado agrícola brasileiro, essa é uma das etapas mais onerosas do ciclo produtivo. “Além de o pulverizador ser a máquina que mais trabalha na lavoura, a pulverização representa, por exemplo, cerca de 25% do custo total da produção de soja e de até 30% do cultivo de algodão”, ressalta.
O manejo adequado, com apoio de tecnologias de campo, pode evitar o desperdício do produto e ajudar na eficiência operacional. O especialista listou seis práticas importantes para tornar o processo mais eficiente e trazer ganhos na produtividade e na rentabilidade do agricultor.
- Altura correta das barras em relação ao alvo: as barras muito elevadas ou próximas do alvo podem causar perdas de aproximadamente duas sacas por hectare. Se a barra é posicionada acima da altura correta, é possível ter perdas por deriva e, posicionada muito abaixo, o alvo pode não ser atingido. Para definir a altura ideal é preciso analisar o tipo de ponta utilizada e o ângulo do jato, além do espaçamento entre elas.
- Estabilidade da barra: a estabilidade da barra em aplicações que chegam a atingir velocidade acima de 15 km/h tende a diminuir, acarretando falhas na aplicação e perda de produtividade que podem chegar de cinco a setes sacas por hectare em soja, por exemplo. O uso de tecnologias, como o sensor de alturas de barras, é importante para auxiliar na estabilidade.
- Condições climáticas: a condição climática é importante para a decisão do momento exato para a aplicação do produto. Atualmente, existem monitores climáticos portáveis e estações meteorológicas instaladas nas lavouras que fornecem dados sobre a temperatura, umidade relativa do ar e vento, três fatores que garantem uma aplicação eficiente. No padrão ideal para aplicação, a velocidade do vento deve ser de 2 km/h a 10 km/h, a temperatura máxima em torno de 30°C e a umidade relativa do ar acima de 50%.
- Escolha correta das pontas de pulverização: Para escolher as pontas de pulverização, o produtor precisa definir o alvo: praga, doença ou planta daninha. Após a definição, é importante consultar um engenheiro agrônomo para escolher o produto que será aplicado e saber a forma como ele age na praga ou na cultura. Existem defensivos sistêmicos, que agem diretamente na fisiologia da planta. Para esse tipo de produto pode ser utilizado, em alguns casos, pontas que forneçam gotas um pouco maiores, diminuindo o risco de deriva. Já para produtos de contato, o indicado são pontas que forneçam gotas menores para proporcionar uma área de cobertura maior, neste caso é muito importante estar atento às condições climáticas.
- Desgaste de pontas de pulverização: o critério que deve ser adotado é o desgaste proveniente de vários fatores como qualidade da água, pressão de trabalho, poder abrasivo de produtos e limpeza. É recomendável a troca quando a ponta de pulverização apresenta acima de 10% de sua vazão nominal. Não realizar a troca no momento correto pode ocasionar aumento significativo do custo da aplicação e maior dano ambiental.
- Dimensionamento de máquinas para aplicação: é muito importante o correto dimensionamento dos pulverizadores de acordo com as características das áreas e logística das propriedades. Atraso de sete dias na decisão de aplicação do fungicida em soja, por exemplo, pode resultar no aumento da severidade da Ferrugem asiática e na redução da produtividade, que pode chegar a três sacas de 60 kg por hectare, segundo estudo em algumas instituições.
Pulverizador MF 9330 – Para evitar desperdícios de insumos, com pulverização uniforme e qualidade assertiva, a Massey Ferguson oferece o pulverizador MF 9330. Com tanque de calda de 3.000 litros e barra de pulverização de 24 ou 30 metros, o modelo propicia uma melhor deposição das gotas pulverizadas, garantindo uma produtividade que pode superar cinco sacas por hectare com o uso do sistema de controle automático de altura e nivelamento de barras. O motor AGCO Power de 200 cv consome até 30% menos combustível em relação a modelos do mercado e o sistema robusto de tração com bomba dupla cruzada permanente aliado ao chassi flexível permite que o modelo enfrente terrenos adversos mantendo a qualidade da aplicação.